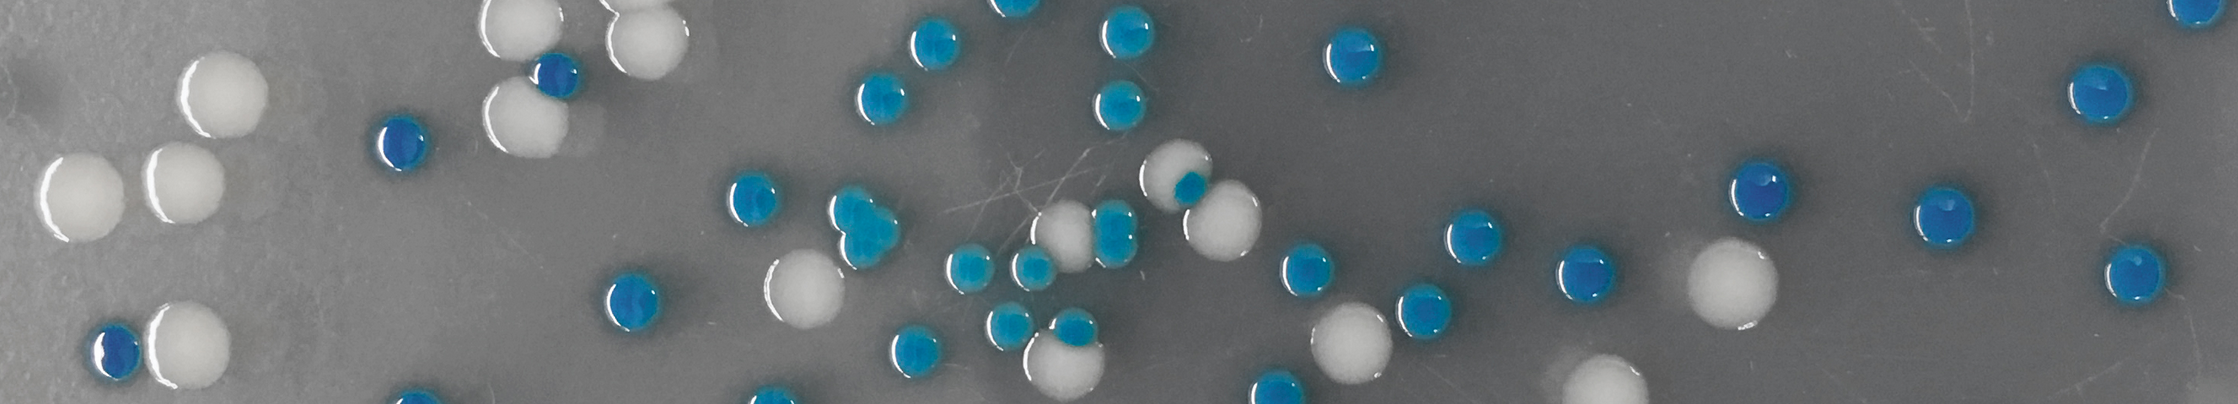

Syllabus
Textbook readings from Evolution by Bergstrom and Dugatkin.
Date | Week | Topic | Due | Slides | Reading |
---|---|---|---|---|---|
1/6/2020 | 1 | Student lightning talks, RP & VO vision of course | -- | -- | "Beak of the Finch", Dobzhansky 1976 |
1/7/2020 | Lab | Crafting the history of life on Earth | -- | -- | |
1/8/2020 | 1 | What is evolution? The facts. The theory (RP) | -- | -- | |
1/13/2020 | 2 | Darwin the geobiologist. Reading the rock record (VO) | -- | Chapter 4 | |
1/14/2020 | Lab | Which came first, the chicken or the finch? Part I | -- | -- | |
1/15/2020 | 2 | Species concept and phylogeny (VO) | HW 1 | ||
1/22/2020 | 3 | Holiday - no class | -- | -- | |
1/21/2020 | Lab | Which came first, the chicken or the finch? Part II | -- | -- | |
1/22/2020 | 3 | Whales as a success story for illustrating evolution (RP) | HW 2 | -- | |
1/27/2020 | 4 | Mechanisms of speciation (VO) | -- | -- | Chapter 14 |
1/28/2020 | Lab | Population genetics computational exploration | -- | -- | |
1/29/2020 | 4 | Convergent evolution (RP) | HW 3 | -- | |
2/3/2020 | 5 | Population genetics: Introduction (RP) | -- | -- | |
2/4/2020 | Lab | Luria-Delbruck part I | -- | -- | Chapter 6, pg 204-207 |
2/5/2020 | 5 | Population genetics: Drift and the Wright-Fisher model (RP) | -- | -- | |
2/10/2020 | 6 | Population genetics: Analogies to Einstein’s diffusion equation (RP) | -- | -- | |
2/11/2020 | Lab | Luria-Delbruck part II | -- | -- | |
2/12/2020 | 6 | Major transitions in evolution (VO) | HW 4 | -- | |
2/17/2020 | 7 | Holiday - no class | -- | -- | |
2/18/2020 | Lab | Debate Prep | -- | -- | |
2/19/2020 | 7 | In class debate on the origin of eukaryotes | HW 5 | -- | |
2/24/2020 | 8 | Super-logarithms (RP) | -- | -- | |
2/25/2020 | Lab | Evolving promoters part I | -- | -- | |
2/25/2020 | 8 | Human evolution (RP) | -- | -- | |
3/2/2020 | 9 | Co-evolution (VO) | -- | -- | Chapter 18 |
3/3/2020 | Lab | Visit bird lab at Occidental College | -- | -- | |
3/4/2020 | 9 | Mutualistic and antagonistic interactions (VO) | HW 6 | -- | Chapter 18, continued |
3/9/2020 | 10 | Guest lecture from Shana Goffredi on animal-microbe symbioses | -- | -- | |
3/10/2020 | Lab | Evolving promoters part II | -- | -- | |
3/11/2020 | 10 | Guest lecture from Joe Parker | -- | -- |